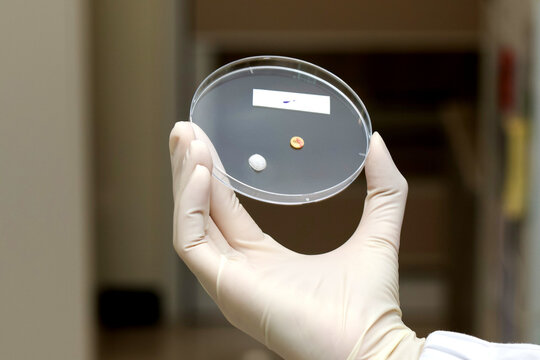
Gloved hand petri dish laboratory pill tablet antibiotic sterile clinical research medical sample with focused precision

- Home >
- Stock Photos >
- Healthcare Professional Analyzing Data on Digital Tablet in Hospital Corridor
Healthcare Professional Analyzing Data on Digital Tablet in Hospital Corridor Image

AI Generated Image. Visual focuses on a healthcare professional wearing blue scrubs, holding and concentrating on a digital tablet. She stands in a softly lit hospital corridor with monitors emitting a gentle glow, emphasizing modern medical technology. Useful for illustrating themes of healthcare innovation, digital diagnostics, electronic health management, and medial professionalism. Ideal for hospitals, healthcare organizations, medical technology companies, or educational material focusing on medical data and digital advancements.
0
downloads
downloads
Tags:
More
Credit Photo
If you would like to credit the Photo, here are some ways you can do so
Text Link
photo Link
<span class="text-link">
<span>
<a target="_blank" href=https://pikwizard.com/photo/healthcare-professional-analyzing-data-on-digital-tablet-in-hospital-corridor/03a60d4d5247a3deb1e990fcbd9aad22/>PikWizard</a>
</span>
</span>
<span class="image-link">
<span
style="margin: 0 0 20px 0; display: inline-block; vertical-align: middle; width: 100%;"
>
<a
target="_blank"
href="https://pikwizard.com/photo/healthcare-professional-analyzing-data-on-digital-tablet-in-hospital-corridor/03a60d4d5247a3deb1e990fcbd9aad22/"
style="text-decoration: none; font-size: 10px; margin: 0;"
>
<img src="https://pikwizard.com/pw/medium/03a60d4d5247a3deb1e990fcbd9aad22.jpg" style="margin: 0; width: 100%;" alt="" />
<p style="font-size: 12px; margin: 0;">PikWizard</p>
</a>
</span>
</span>
Free (free of charge)
Free for personal and commercial use.
Author: AI Creator